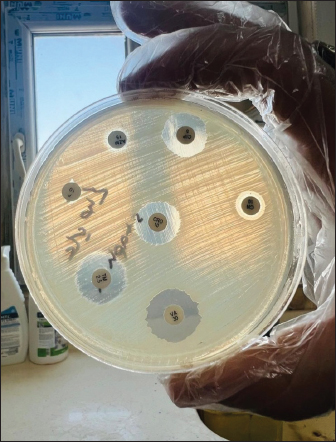

| Research Article | ||
Open Vet. J.. 2025; 15(12): 6224-6229 Open Veterinary Journal, (2025), Vol. 15(12): 6224-6229 Research Article Antibacterial activity of orange peel extract against Staphylococcus aureus in vitroSaad Saleem Raheem1*, Alaa Hashim Abd Ali2, Marwa Fadhil Al-Saffar3, Zahraa Mohammed Ayad5, Oday M. Hadi41Department of Community Health, College of Health and Medical Technology, Al-Furat Al-Awsat Technical University, Kufa, Iraq 2Department of Pathological Analysis, College of Health and Medical Technology, Al-Furat Al-Asat Technical University, Kufa, Iraq 3Medical Laboratories Techniques Department, College of Health & Medical Techniques, Al-Mustaqbal University, Hillah, Iraq 4Department of Community Health, College of Health and Medical Technology, Al-Furat Al-Awsat Technical University, Kufa, Iraq 5Department of Physiology and Biochemistry and Pharmacology, College of Veterinary Medicine, Al-Qasim Green University, Babylon, Iraq *Corresponding Author: Saad Saleem Raheem. Department of Community Health, College of Health and Medical Technology, Al-Furat Al-Awsat Technical University, Kufa, Iraq. Email: kuh.sad [at] atu.edu.iq Submitted: 19/09/2025 Revised: 11/11/2025 Accepted: 15/11/2025 Published: 31/12/2025 © 2025 Open Veterinary Journal
AbstractBackground: Opportunistic Staphylococcus aureus (S. aureus) may cause a range of infections in humans and animals, from self-limiting to life-threatening. S. aureus might be acquired from food via contaminated hands or food contact surfaces. Orange peel extract has various therapeutic uses. Aim: This study aimed to estimate the antibacterial activity of orange peel extract against S. aureus in vitro by measuring the inhibition zone and minimum inhibitory concentrations (MICs). Methods: Staphylococcus aureus was isolated from food contact surfaces on mannitol salt agar in Kufa, Iraq. An aqueous extract of orange peel was prepared. The antimicrobial activities of the orange peel extracts against the recovered S. aureus isolates were tested using the agar well diffusion method by measuring the diameters of the inhibition zone on nutrient agar. Results: The results showed significant antibacterial activity (p < 0.05) of orange peels extract at different concentrations. All tested concentrations (10–100 mg/ml) had clear antimicrobial activities against S. aureus. The MIC recorded was 10 mg/ml. Such antimicrobial activities were comparable to those of the tested antimicrobials, such as trimethoprim, vancomycin, ciprofloxacin, and chloramphenicol. The lowest anti-S. aureus activities were recorded for azithromycin and clindamycin, with no anti-S. aureus activity for tobramycin. Conclusion: Orange peel extract had antibacterial activity against S. aureus. The correlation of the exponential increase in the diameter of the inhibition zone with increasing the extract concentrations of orange peel extract was well-marked. Therefore, orange peel extracts can be used in food preparations and hand washes to inhibit S. aureus growth. Keywords: Orange peel extract, Staphylococcus aureus, Antibacterial activity, Antibiotics, Minimum inhibitory concentrations. IntroductionHealthy individuals who are transferors can become asymptomatically (Smith, 2015) conquered by Staphylococcus aureus (Hasson et al., 2022). Staphylococcus aureus is a member of the gram-positive Staphylococcus genus in the Bacillales order of bacteria. At least 40 species in the genus Staphylococcus are significant to veterinarians. Antimicrobial resistance profiles, ecological, epidemiological, and pathogenicity characteristics differ greatly between species and even between separate of identical types (Leroy et al., 2015; Salman et al., 2022). Staphylococcus aureus is an innocuous bacterium that often lives on human and animal mucous membranes, skin, and food contact surfaces. This infection exists all over the globe. The risk of methicillin-resistant Staphylococcus aureus (MRSA) infection is increased by infection rates in community settings and among nursing home patients (Jacquemyn et al., 2013). Opportunistic S. aureus may cause a range of infections in people and animals, from self-limiting to life-threatening. Staphylococcus aureus pathogenesis includes colonization, local infection, sepsis, and/or systemic spread, metastatic infections, and toxicosis. The neutrophil response is the main defense mechanism against S. aureus infection. Bacterial skin and soft tissue infections can appear clinically as superficial diseases, seriously invasive infections, or widespread illnesses (Ray et al., 2013). In recent years, Staphylococci have evolved an extensive number of resistance genes that contribute to their antibiotic resistance. The mecA gene, which produces penicillin-binding proteins (PBPs)-2A, a PBP, causes methicillin resistance. The staphylococcal cassette chromosome is home to this gene. The size and genetic makeup of the staphylococcal cassette chromosome, another significant genetic movable element, differ among MRSA strains (Shore and Coleman, 2013). Antimicrobial medications have two effects: they either eradicate bacteria (microbicidal) or stop them from growing (microbistatic). Antimicrobial compounds called disinfectants are applied to inanimate things (Ahmed, 2006). As a byproduct of fruit processing, orange peel is a good source of bioactive ingredients (Mamta and Parminder, 2013). Substances made from citrus fruit have strong antibacterial and fungal qualities (Singh, 2011). Citrus fruits are an excellent source of polymethoxylated flavones and flavonones, which are quite uncommon in other plants (Ahmed, 2006). Certain citrus fruits have been reviewed because of their chemical properties, which have several uses in the global food and pharmaceutical sectors, and not only have significant physiological functions but are also of financial significance (Mathur et al., 2011). Orange peel extract has a wide range of therapeutic uses, involving antibacterial actions, colic management, upset stomach, cancer prevention, diuretic, cormunative, immuno-enhancing, stomachic, and tonic effects on the skin, immunological system, and digestive system. Additionally, it helps fight bacterial and viral infections and is used to treat and prevent vitamin deficiencies, colds, flu, and scurvy (Mehmood et al., 2015). This study aimed to estimate the antibacterial activity of orange peel extract against S. aureus in vitro by measuring the inhibition zone and minimum inhibitory concentrations (MICs). Materials and MethodsBacterial isolatesStaphylococcus aureus was harvested from food contact surfaces in Kufa, Iraq. The organisms were subcultured on mannitol salt agar and incubated at 37oC for 18–24 hours. Bacterial countStaphylococcus aureus is counted by The McFarland solution was found in tube number 0.5, in accordance with the instructions provided by Xuan Qin et al. (2004). The standard McFarland solution No.0.5 was prepared as follows: Solution (A) was prepared by dissolving 1.175 g of barium chloride (BaCl2.2H2O) in 100 ml of distilled water prior to its preparation. Solution (B) was prepared by adding 1 ml of concentrated sulfuric acid (H2SO4) to 100 ml of distilled water. A total of 99.5 ml of solution B was combined with 0.5 ml of solution A to create a mixture of the two solutions. A comparison was made between the turbidity of the bacterial suspension and the prepared solution, resulting in an approximate cell density of 1.5 × 108 cells/ml. Preparation of orange peel hot water extract (aqueous extraction)The orange peel extract was prepared as follows: The extraction method that was employed (Kafle and Shih, 2013) was followed. For a brief summary, 15 g of the powdered plant was soaked individually in 200 ml of distilled water at room temperature for 24 hours while being shaken consistently. After that, the extract was filtered through Whitman filter paper No. 1 and then concentrated to dryness in a water bath at a temperature of 70°C. The Shimadzu weighing balance was used to determine the amount of extract produced. Each extract was placed in a glass vial and stored at a temperature of 4°C before use. To prepare the stock solution of orange peel extract, 10 g of dry extract was dissolved in 100 ml of hot boiling water (weight-to-volume). The antibacterial test (sensitivity tests)The anti-staphylococcal activity of the orange peel extract at different concentrations was evaluated using an agar well diffusion test (Abalaka and Bello, 2016). Kirby-Bauer disk diffusion susceptibility testing methodology was used for various antibiotics (azithromycin, clindamycin, chloramphenicol, ciprofloxacin, piperacillin, tobramycin, trimethoprim, and vancomycin) (Table 1). A recognized standard method, such as those issued by the USA National Committee for Clinical Laboratory Standards Institute (CLSI), must be employed for routine S. aureus susceptibility testing (CLSI, 2023). Table 1. Antibiotics tested and their concentrations in this study.
The MIC of orange peel extract was determined for the isolates of S. aureus according to EUCAST (2019). Bacterial media inoculationTo evaluate the antibacterial efficacy of the hot water extract of orange peels against S. aureus, 8-mm-diameter wells were created in the solid medium using a metallic apparatus. The wells were then filled with varying concentrations of the orange peel extract from each sample, with each well containing 100 l. The bacteria-containing plates were kept in an incubator at 37°C for 24 hours. The diameter of the inhibitory zones was obtained in mm following the incubation period (Qin et al., 2004). Statistical analysisThe statistical package SPSS 8.0 was used to perform all statistical analyses. The independent sample F-test and the one-way analysis of variance were used to compare the values between the different groups. P values of 0.05 were considered statistically significant, according to the least significant difference method (Daniel and Cross, 2014). Ethical approvalAll experiments were conducted in accordance with the ethical guidelines of Al-Qasim Green University, Research Ethics Committee Biotechnology College building, AL-Qasim, Babylon, Iraq, 51013. HYPERLINK "mailto:qgec [at] uoqasim.edu.iq" qgec [at] uoqasim.edu.iq. Certificate No.: qgec/46 /2025, Date of Approval: 3 /12 / 2025, Expiration date: 3/13/2026. ResultsAll concentrations of hot water extract of orange peels extract that were used in this study had a significant inhibitory effect on S. aureus isolates recovered from food contact surfaces (p < 0.05), at a concentration range of 10–100 mg/ml (Table 2). The MIC of the orange peel extract used was 10 mg/ml. The inhibition zones corresponded to the peel extract concentration, as shown in Figures 1 and 2. Regarding the tested antimicrobial against South aureus, the highest antibacterial activity properties appeared in trimethoprim and vancomycin (21.96 ± 0.61, and 20.3 ± 0.95), respectively. The least inhibitory zones were recorded for azithromycin and clindamycin (0.92 ± 0.03, 0.61 + 0.05) (Fig. 3, Table 3).
Fig. 1. Sensitivity testing of orange peel extract at 30 and 70 mg/ml against Staphylococcus aureus.
Fig. 2. Sensitivity testing of orange peel extract at 10 and 90 mg/ml against Staphylococcus aureus.
Fig. 3. Sensitivity testing of antibiotics with inhibition zones against S. aureus. Table 2. Diameter of inhibition zone (mm.) of different concentrations of extracted orange peels against S. aureus.
Table 3. Diameter of the inhibition zone (mm.) of different types of antibiotics against S. aureus.
DiscussionAccording to Tao (2007), citrus is one of the most significant commercial fruit crops grown in every country on the planet. Anti-S. aureus activity was found to be considerable in the tested extract. This finding is in agreement with those of Obidi et al. (2013) and Shetty et al. (2016) who clarified that such inhibitory effects could be attributed to the composition of the active ingredients, which includes D-lemonene, cyclohexane, 1-methylene-4-(1-methylethenyl; bicyclo[4,1,0] hept-2-ene, 3-7-7 trimethyl; 1, 6 octadien-3-ol, 3,7 dimethyl-1,2-aminobanzoate; 3-cyclohexane-1-ol, 2-methyl -5-(1-methylethyl); 2-furanastic acid, 4-hexyl-2, 5-dihydro-2,5-dioxo; naphthalene, 1,2,3,5,6, 8a-hexahydro-4,7-dimethyl- 1-(1-methlethyl) -, (1S-cis) and n-hexadecanoic acid) structure, as well as the functional groups of the oils play a significant role in determining their antimicrobial activity (Zaki et al., 2022). Additionally, the antibacterial activity of orange peel extract against S. aureus could be caused by sensitizing the cell membrane, increasing permeability, leaking critical intracellular components, and affecting the bacterial enzyme system and cell respiration (Moreira et al., 2005). These are all potential mechanisms of action. The value of 10 mg/ml was considered the MIC for the orange peel extract because it formed an inhibition zone of 1.3 + 0.03 mm against S. aureus isolates. According to Abalaka and Bello (2016), alkaloids, terpenens, flavonoids, reducing sugar, saponins, tannins, and glycocides were among the active components discovered through phytochemical screening of orange peel. These components may be responsible for the antibacterial characteristics of orange peel, which could be linked to their existence. As an illustration, research has shown that the saponin found in orange peel interferes with the replication of DNA and that the glycogen is digested to generate phenol compounds and acids that have antibacterial effects (Kumar et al., 2011). The antibacterial effects of vancomycin and trimethoprim were in agreement with those of the study conducted by Stogios and Savchenko (2020). This investigation confirmed that vancomycin, which is currently regarded to be clinically authorized, is effective in the treatment of MRSA infection. These glycopeptide antibiotics work on the bacterial cell wall in the same way that beta-lactams do, but their mode of action is different: they connect to the peptidoglycan side chain and prevent crosslinking (Hawraa H. Naji et al., 2021). The drug susceptibility test outcomes were quite similar to the antibacterial inhibition zones tested for chloramphenicol and ciprofloxacin. In accordance with Otto’s (2010) theory, which demonstrated that methicillin-resistant Staphylococcus may acquire multiple drug resistance if additional resistance genes, such as aadD, which codes for an enzyme that resists tobramycin, are integrated into the IS431mec SCCmec cassette, the findings of the current investigation are consistent with the same theory. Tobramycin did not exhibit any antibacterial activity on the pathogen that was examined. This drug resistance can be explained by pointing out that certain infections develop resistance to aminoglycosides by altering the therapeutic target site. Aminoglycoside phosphotransferase, nucleotidyltransferase, and acetyltransferases are the three enzymes that can alter and reduce the effectiveness of tobramycin (Reyhanoglu and Reddivari, 2023). ConclusionOrange peel extract had antibacterial activity against S. aureus. The correlation between the exponential increase in the diameter of the inhibition zone with increasing the extract concentrations of orange peel extract against S. aureus was well-marked. AcknowledgmentsNone. Conflict of interestThe authors declare that there is no conflict of interest. FundingNot applicable. Authors’ contributionsAll authors contributed equally. Data availabilityAll data are within the manuscript. ReferencesAbalaka, M.E. and Bello, A.O. 2016. Antibacterial activity of Citrus sinensis (Orange) peel on bacterial isolates from wound. UMYU. J. Microbiol. Res. 1(1), 161–168. Ahmed, A. 2006. Genetic variability to essential oil composition in four Citrus fruit species. Pak. J. Bot. 38(2), 319–324. CLSI. 2023. Performance Standards for Antimicrobial Testing 33rd. CLSI. Supplement M100. Clinical and Laboratory Standards Institute, USA. Daniel Wayne, W. and Chad, L.C. 2014. Foundation for Analysis in the Health science. 11 edition. Hobkinen, NJ: Wiley. Daniel, W.W. and Cross, C L. 2014. Biostatistics: basic concepts and methodology for the health sciences, 10th ed. Hoboken, NJ: Wiley. EUCAST 2019. Breakpoint Tables for Interpretation of MICs and Zone Diameters. Denmark: The European Committee on Antimicrobial Susceptibility Testing. Hasson, S.O., Jasim, A.M., Salman, S.A.K., Akrami, S., Saki, M. and Hassan, M.A. 2022. Evaluation of antibacterial and wound-healing activities of alcoholic extract of Boswellia carterii, in vitro and in vivo study. J. Cosm. Dermatol. 21(11), 6199–6208. Hawraa H. Naji., Eman Jawad Jabber. and Adnan M Jasim. 2021. The Effect of Saliva Officinalis L (Sage Tea) on Biochemical and Pathological Changes Improvment in Adult Male Rats Induced by a High Fat Diet. Ind. J. Foren. Med. Toxicol. 15(3), 3. Jacquemyn, H., Lenaerts, M., Brys, R., Willems, K., Honnay, O. and Lievens, B. 2013. Among-population variation in microbial community structure in the floral nectar of the bee-pollinated forest herb Pulmonaria officinalis L. PLos One 8(3), e56917. Kafle, L. and Shih, C.J. 2013. Toxicity and repellency of compounds from clove (Syzygium aromaticum) to red imported fire ants Solenopsis invicta (Hymenoptera: formicidae). J. Econ. Entomol. 106(1), 131–135. Kumar, K.A., Subanthini, A. and Jayakumar, M. 2011. Antimicrobial Activity and Phytochemical Analysis of Citrus Fruits Peel. Utiliz. Fruits Waste, 3(6), 5414-5421 Leroy, F., Van Coillie, E., Braem, G., Piessens, V. and Verbist, B. 2015. Subtyping of Staphylococcus haemolyticus isolates from milk and corresponding teat apices to verify the potential teat-skin origin of intramammary infections in dairy cows. J. Dairy. Sci. 98(11), 7893–7898. Mamta, A. and parminder, K. 2013. Antimicrobial and anti-oxidant activity of orange pulp and peel. Inter. J. Sci. Res. 11, 2319. Mathur, A., Purohit, R., Mathur, D., Prasad, G.B.K.S. and Dua, V.K. 2011. Pharmacological investigation of methanol extract of Syzygium cuminii seeds and Crateva nurvula bark on the basis of antimicrobial, antioxidant and anti-inflammatory properties. Der. Chemica. Sinica. 2(1), 174–181. Mathur, A., Verma, R., Purohit GBKS Prasad., Mathur, V., Gupta, V.K., Dua., Moreira, M.R., Ponce, A.G., De Valle, C.E. and Roura, S.I. 2005. Inhibitory parameters of essential oils to reduce a foodborne pathogen. Lebensmittel-Wissenschaft. Und -Technologie-LWT 38, 565–570. Mehmood, B., Dar, K.K., Ali, S., Awan, U.A., Nayyer, A.Q., Ghous, T. and Andleeb, S. 2015. Short communication: in vitro assessment of antioxidant, antibacterial and phytochemical analysis of peel of Citrus sinensis. Pak. J. Pharm. Sci. 28, 231–239. Moreira, M.R., Ponce, A.G., Del Valle, C.E. and Roura, S.I. 2005. Inhibitory parameters of essential oils to reduce a foodborne pathogen. LWT – Food Sci. Tech. 38(5), 565–570; doi:10.1016/j.lwt.2004.07.012 Obidi, O.F., Adelowotan, A.O., Ayoola, G.A., Johnson, O.O., Hassan, M.O. and Nwachukwn Otto, M. 2010. Staphylococcus aureus toxin gene hitchhikes on a transferable antibiotic resistance element. J. Virul. 1(1), 49–51. Obidi, O.F., Adelowotan, A.O., Ayoola, G.A., Johnson, O.O., Hassan, M.O. and Nwachukwu, S.C.U. 2013. Antimicrobial activity of orange oil on selected pathogens. Int. J. Biotechnol. 2(6), 113–122. Otto, M. 2010. Basis of virulence in community-associated methicillin-resistant Staphylococcus aureus. Annu. Rev. Microbiol. 64, 143–162. Qin, X., Weissman, S.J., Chesnut, M.F., Zhang, B. and Shen, L. 2004. Kirby-Bauer disc approximation to detect inducible third-generation cephalosporin resistance in Enterobacteriaceae. Ann. Clin. Microbiol. Antimicrobials 3, 13. Ray, G.T., Suaya, J.A. and Baxter, R. 2013. Microbiology of skin and soft tissue infections in the age of community-acquired methicillin-resistant Staphylococcus aureus. Diagn. Microbiol. Infect. Dis. 76(1), 24–30. Reyhanoglu, G. and Reddivari, A.K.R. 2023. Tobramycin. [Updated 2025 Aug 12. Treasure Island (FL): StatPearls Publishing; 2024 Jan-. Available from: https://www.ncbi.nlm.nih.gov/books/NBK551695/# Salman, S.A.K., Taki, M.M., Hadi, S.J. and Jasim, A.M. 2022. Green synthesis and Characterization of Zinc Nanoparticles using Herbal plant Extracts with their Influence on some Bacterial Infection. Res. J. Pharm. Technol. 15(7), 3147–3152. Shetty, S.B., Mahin-Syed-Ismail, P., Varghese, S., Thomas-George, B., Kandathil-Thajuraj, P., Baby, D., Haleem, S., Sreedhar, S. and Devang-Divakar, D. 2016. Antimicrobial effects of Citrus sinensis peel extracts against dental caries bacteria: an in vitro study. J. Clin. Exp. Dent. 8(1), e71–e77. Shore, A.C. and Coleman, D.C. 2013. Staphylococcal cassette chromosome mec: recent advances and new insights. Inter. J. Med. Microbiol. 303(6-7), 350–359. Singh. 2011. Evaluation of in vitro antimicrobial and antioxidant properties of some citrus fruits. IJPI’s. J. Biotechnol. Biotherap. 1(2), 1–17. Smith, T.C. 2015. Livestock-associated Staphylococcus aureus: the United States experience. PLos Pathog. 11, e1004564. Stogios, P.J. and Savchenko, A. 2020. Molecular mechanisms of vancomycin resistance. Protein Sci. 29(3), 654–669. Tao, K. 2007. Chemical composition of essential oil from the peel of Satsuma mandarin. Afri. J. Biotechnol. 7, 1261–1264. Zaki, M.R., Farrag, T.E., Mohamedin A.H., El-Bana, M.I. and Saber, W.I.A. 2022. Antibacterial Activity of Fruit Peels Extracts against Pathogenic Bacteria. Faculty of Science Port Said University. Port Said city, Egypt. | ||
| How to Cite this Article |
| Pubmed Style Raheem SS, Ali AHA, Al-saffar MF, Ayad ZM, Hadi OM. Antibacterial activity of orange peel extract against Staphylococcus aureus in vitro. Open Vet. J.. 2025; 15(12): 6224-6229. doi:10.5455/OVJ.2025.v15.i12.6 Web Style Raheem SS, Ali AHA, Al-saffar MF, Ayad ZM, Hadi OM. Antibacterial activity of orange peel extract against Staphylococcus aureus in vitro. https://www.openveterinaryjournal.com/?mno=291459 [Access: January 25, 2026]. doi:10.5455/OVJ.2025.v15.i12.6 AMA (American Medical Association) Style Raheem SS, Ali AHA, Al-saffar MF, Ayad ZM, Hadi OM. Antibacterial activity of orange peel extract against Staphylococcus aureus in vitro. Open Vet. J.. 2025; 15(12): 6224-6229. doi:10.5455/OVJ.2025.v15.i12.6 Vancouver/ICMJE Style Raheem SS, Ali AHA, Al-saffar MF, Ayad ZM, Hadi OM. Antibacterial activity of orange peel extract against Staphylococcus aureus in vitro. Open Vet. J.. (2025), [cited January 25, 2026]; 15(12): 6224-6229. doi:10.5455/OVJ.2025.v15.i12.6 Harvard Style Raheem, S. S., Ali, . A. H. A., Al-saffar, . M. F., Ayad, . Z. M. & Hadi, . O. M. (2025) Antibacterial activity of orange peel extract against Staphylococcus aureus in vitro. Open Vet. J., 15 (12), 6224-6229. doi:10.5455/OVJ.2025.v15.i12.6 Turabian Style Raheem, Saad Saleem, Alaa Hashim Abd Ali, Marwa Fadhil Al-saffar, Zahraa Mohammed Ayad, and Oday M. Hadi. 2025. Antibacterial activity of orange peel extract against Staphylococcus aureus in vitro. Open Veterinary Journal, 15 (12), 6224-6229. doi:10.5455/OVJ.2025.v15.i12.6 Chicago Style Raheem, Saad Saleem, Alaa Hashim Abd Ali, Marwa Fadhil Al-saffar, Zahraa Mohammed Ayad, and Oday M. Hadi. "Antibacterial activity of orange peel extract against Staphylococcus aureus in vitro." Open Veterinary Journal 15 (2025), 6224-6229. doi:10.5455/OVJ.2025.v15.i12.6 MLA (The Modern Language Association) Style Raheem, Saad Saleem, Alaa Hashim Abd Ali, Marwa Fadhil Al-saffar, Zahraa Mohammed Ayad, and Oday M. Hadi. "Antibacterial activity of orange peel extract against Staphylococcus aureus in vitro." Open Veterinary Journal 15.12 (2025), 6224-6229. Print. doi:10.5455/OVJ.2025.v15.i12.6 APA (American Psychological Association) Style Raheem, S. S., Ali, . A. H. A., Al-saffar, . M. F., Ayad, . Z. M. & Hadi, . O. M. (2025) Antibacterial activity of orange peel extract against Staphylococcus aureus in vitro. Open Veterinary Journal, 15 (12), 6224-6229. doi:10.5455/OVJ.2025.v15.i12.6 |